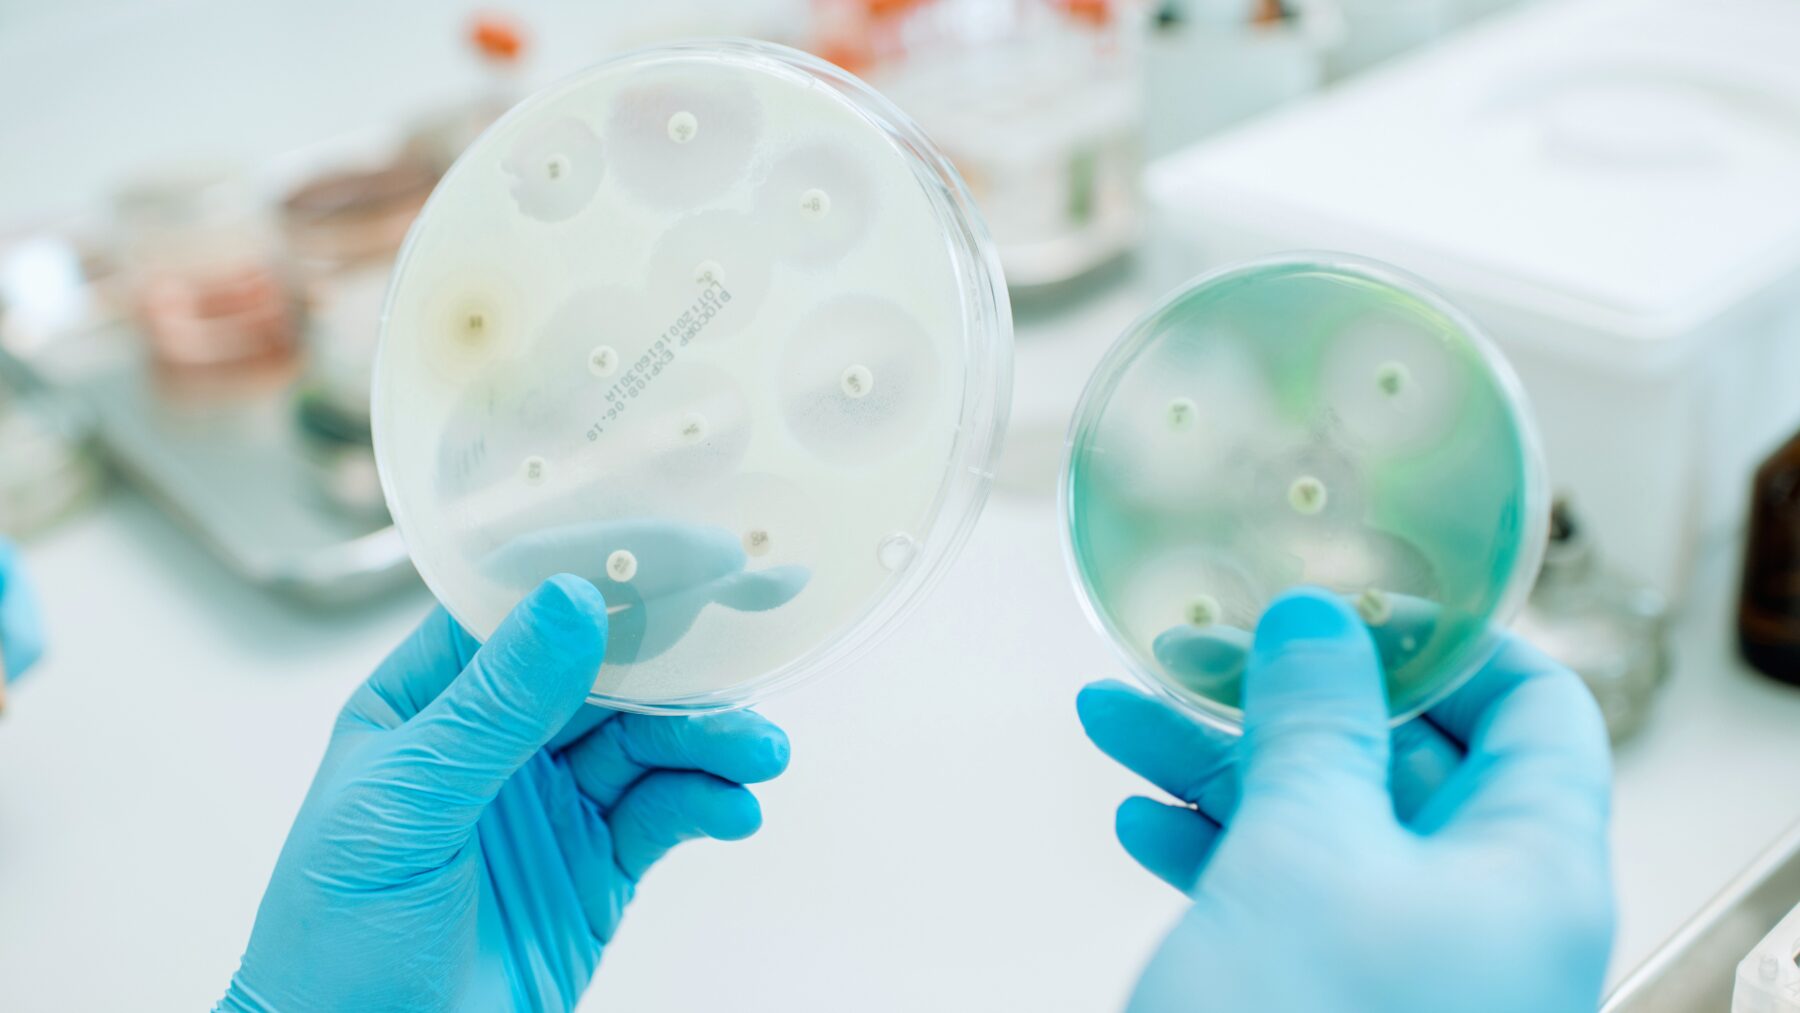
cosisifad_antibiotici

Home / Formazione
Formazione
Al giorno d’oggi, un progetto di informazione indipendente sul farmaco non può prescindere dall’accompagnamento di attività formative che consentano di applicare le conoscenze acquisite nella pratica quotidiana.
Per questo motivo, qui sono raccolti via via i corsi di formazione a distanza sviluppati nell’ambito del progetto COSIsiFA. L’offerta formativa è pensata per rispondere alle esigenze sia degli operatori sanitari sia dei cittadini, aiutandoli a diventare più consapevoli e attivi nella gestione della propria salute.
Corsi per gli operatori sanitari
Revisione della terapia e riduzione dei farmaci nell’anziano
Secondo i dati OsMed del 2023, il 68% degli over 65 ha ricevuto prescrizioni di almeno 5 farmaci in un anno e quasi un anziano su tre ha assunto 10 o più principi attivi. Un uso così esteso di farmaci espone al rischio di prescrizioni inappropriate, interazioni e scarsa aderenza.
Questo corso FAD fornisce conoscenze aggiornate e strumenti pratici per valutare l’appropriatezza prescrittiva, gestire le interazioni e valutare la possibilità di deprescrivere farmaci, promuovendo una gestione sicura e personalizzata delle terapie nell’anziano.
Questo corso FAD fornisce conoscenze aggiornate e strumenti pratici per valutare l’appropriatezza prescrittiva, gestire le interazioni e valutare la possibilità di deprescrivere farmaci, promuovendo una gestione sicura e personalizzata delle terapie nell’anziano.
Disponibile fino al 31 dicembre 2025
Crediti ECM: 14
Crediti ECM: 14

Corsi di formazione

Cronicità e polifarmacoterapia
Uso appropriato degli antibiotici (con approfondimenti EBM)
L’antibiotico resistenza è una delle maggiori minacce per la salute pubblica a livello globale e l’Italia è tra i Paesi con il più alto consumo di antibiotici in Europa e una prevalenza significativa di batteri resistenti.
L’uso inappropriato di questi farmaci è il principale fattore che favorisce le resistenze, con conseguenze sull’efficacia dei trattamenti e sui costi sanitari. Questo corso di formazione a distanza offre gli strumenti metodologici per comprendere i risultati degli studi condotti al riguardo, con esempi pratici e discussione di casi clinici paradigmatici.
L’uso inappropriato di questi farmaci è il principale fattore che favorisce le resistenze, con conseguenze sull’efficacia dei trattamenti e sui costi sanitari. Questo corso di formazione a distanza offre gli strumenti metodologici per comprendere i risultati degli studi condotti al riguardo, con esempi pratici e discussione di casi clinici paradigmatici.
Disponibile fino al 31 dicembre 2025
Crediti ECM: 12

Corsi di formazione